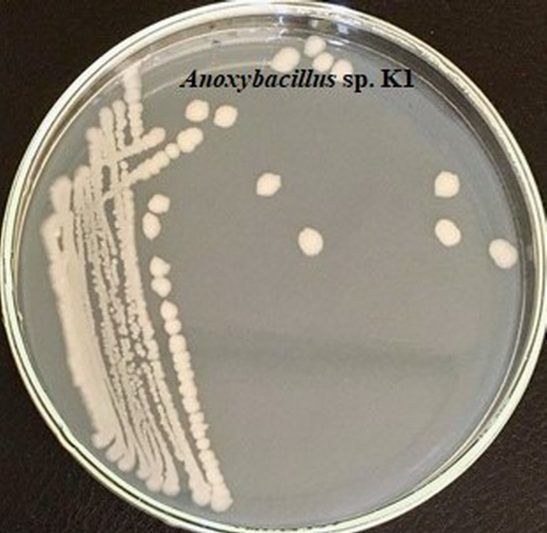

Tras 11 años de investigación científica en la Universidad Estatal de Ereván (YSU) aislaron una nueva bacteria traída de las aguas termales de Karvachar y a la bautizaron con el mismo nombre pero como "Anoxybacillus karvacharensis" y ya es una promesa para la producción de cerveza.
Tras 11 años de investigación científica en la Universidad Estatal de Ereván (YSU) aislaron una nueva bacteria traída de las aguas termales de Karvachar y a la bautizaron con el mismo nombre pero como “Anoxybacillus karvacharensis” y ya es una promesa para la producción de cerveza.
“Anoxybacillus karvacharensis”, una bacteria aún poco conocida en el mundo científico. Llegó al laboratorio de Bioquímica, Microbiología y Biotecnología de la Facultad de Biología de YSU desde las aguas termales de Karvachar. Los científicos del departamento han estado estudiando las bacterias termófilas durante unos 10 años.
“Se diferencia de las especies conocidas, por eso la presentamos como una nueva especie en 2011, y fue aceptada por la sistemática de las bacterias más famosas a nivel internacional”, dijo el Profesor Asociado de la Cátedra, Ph.D. Armine Margaryan.
La temperatura en las aguas termales de Karvachar llega a los 70 grados C, y se ha notado una característica interesante en las bacterias aisladas de aquí.

“La bacteria es productora de la enzima amilasa, que es bastante buena, y las amilasas se utilizan en la producción de cerveza. Estas son las enzimas que intervienen en la descomposición del almidón, por lo que son especialmente importantes para la producción de cerveza. Ofrecemos a los productores que utilicen nuestra bacteria armenia, aislada de la República de Artsaj, en la producción de cerveza, que también puede encontrar su lugar único en la industria farmacéutica”.
No fue fácil nombrar a la bacteria descubierta por científicos armenios en honor a Karvachar, dice Hovik Panosyan, Jefe del Laboratorio de Microbiología Molecular de la Cátedra de Bioquímica, Microbiología y Biotecnología de YSU.
“En nuestro artículo, mencionamos claramente dónde aislamos la bacteria: República de Artsaj, región de Shahumyan, manantial geotérmico de Karvachar. Todos están enumerados en el artículo, aceptados, ratificados internacionalmente. Le dimos a esta bacteria un nombre armenio: “Anoxybacillus karvacharensis”.
El Laboratorio de Biología de YSU envió muestras desde Artsaj a los “bancos” de bacterias en Alemania y Corea del Sur.






